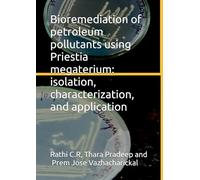
Bioremediation of petroleum pollutants using Priestia megaterium: isolation, characterization, and application

£132.95
Amazon-marketplace.co.uk
Free Delivery

£62.00
amazon.co.uk
Free Delivery

£81.19
Amazon-marketplace.co.uk
Free Delivery

Advances in the Preparation and Characterization Techniques for Developing Coating Materials and Applications
£68.61
amazon.co.uk
Free Delivery

£25.57
Amazon-marketplace.co.uk
Delivery from £2.80

Polyamide Thin Film Composite Membranes for Water Applications: Advanced Characterization Techniques
£21.99
amazon.co.uk
Free Delivery

£123.95
Amazon-marketplace.co.uk
Free Delivery

Characterization Techniques for Polymer Nanocomposites (Polymer Nano-, Micro- and Macrocomposites)
£195.12
Amazon-marketplace.co.uk
Delivery from £5.00

Thin Film Deposition and Characterization Techniques: A Detailed Review of Hydrothermal, Electrodeposition Methods, and Comprehensive Physicochemical Analysis
£39.00
amazon.co.uk
Free Delivery

The Renaissance in GPCR Research and Drug Discovery: Receptor Function, Receptor Structure, New Techniques, Characterization of Drug Activity, Drug Discovery
£141.99
amazon.co.uk
Free Delivery

Recent Advances in Shale Characterization Based on Laboratory Geochemistry and Geomechanics Techniques (SpringerBriefs in Petroleum Geoscience & Engineering)
£44.99
amazon.co.uk
Free Delivery

Seaweed Bioactives: Extraction and Characterization Techniques (Functional Foods and Nutraceuticals)
£160.00
amazon.co.uk
Free Delivery

Characterization of Minerals, Metals, and Materials 2026: In-Situ Characterization Techniques (The Minerals, Metals & Materials Series)
£219.99
amazon.co.uk
Free Delivery

Signal Integrity Characterization Techniques
£14.60
amazon.co.uk
Free Delivery

Characterization of Osmotic Dehydrated Turnip (Brassica rapa) and Radish (Raphanus sativus): Enhancing Shelf Life and Quality of Root Vegetables through Osmotic Dehydration Techniques
£75.00
amazon.co.uk
Free Delivery

£36.43
Amazon-marketplace.co.uk
Delivery from £2.99
Bioremediation of petroleum pollutants using Priestia megaterium: isolation, characterization, and application
£10.52
amazon.co.uk
Free Delivery
🤖 Ask ChatGPT
🛍️ What are the most important purchase criteria?
💰 Tell me the best deals!
📋 Create a short summary!
Informations about "characterization techniques for"
Look at 50 offers for your search.
Pricehunter was able to locate offers in 28 categories, ranging from £10.52 to £219.99.
About "characterization techniques for"
- In total, Pricehunter was able to locate 2 proposals, from suppliers such as Amazon-marketplace.co.uk and amazon.co.uk.
- If you would prefer an item from a particular manufacturers, you can find 4 mail order companies for this product. If you have not yet made a decision, you can also filter your favourite producers and choose between 4 manufacturers.
- The most offers (7) were found in the price range from £130.00 to £139.99.
- Customers who looked for this item also found interesting.
- With our extensive colour palette you can select your favourite colour for your article. Of the available 0 coloration is the most frequently chosen.
Don't forget your voucher code:
Report Illegal Concerns
You are about to report a violation based on the EU Digital Services Act (DSA).